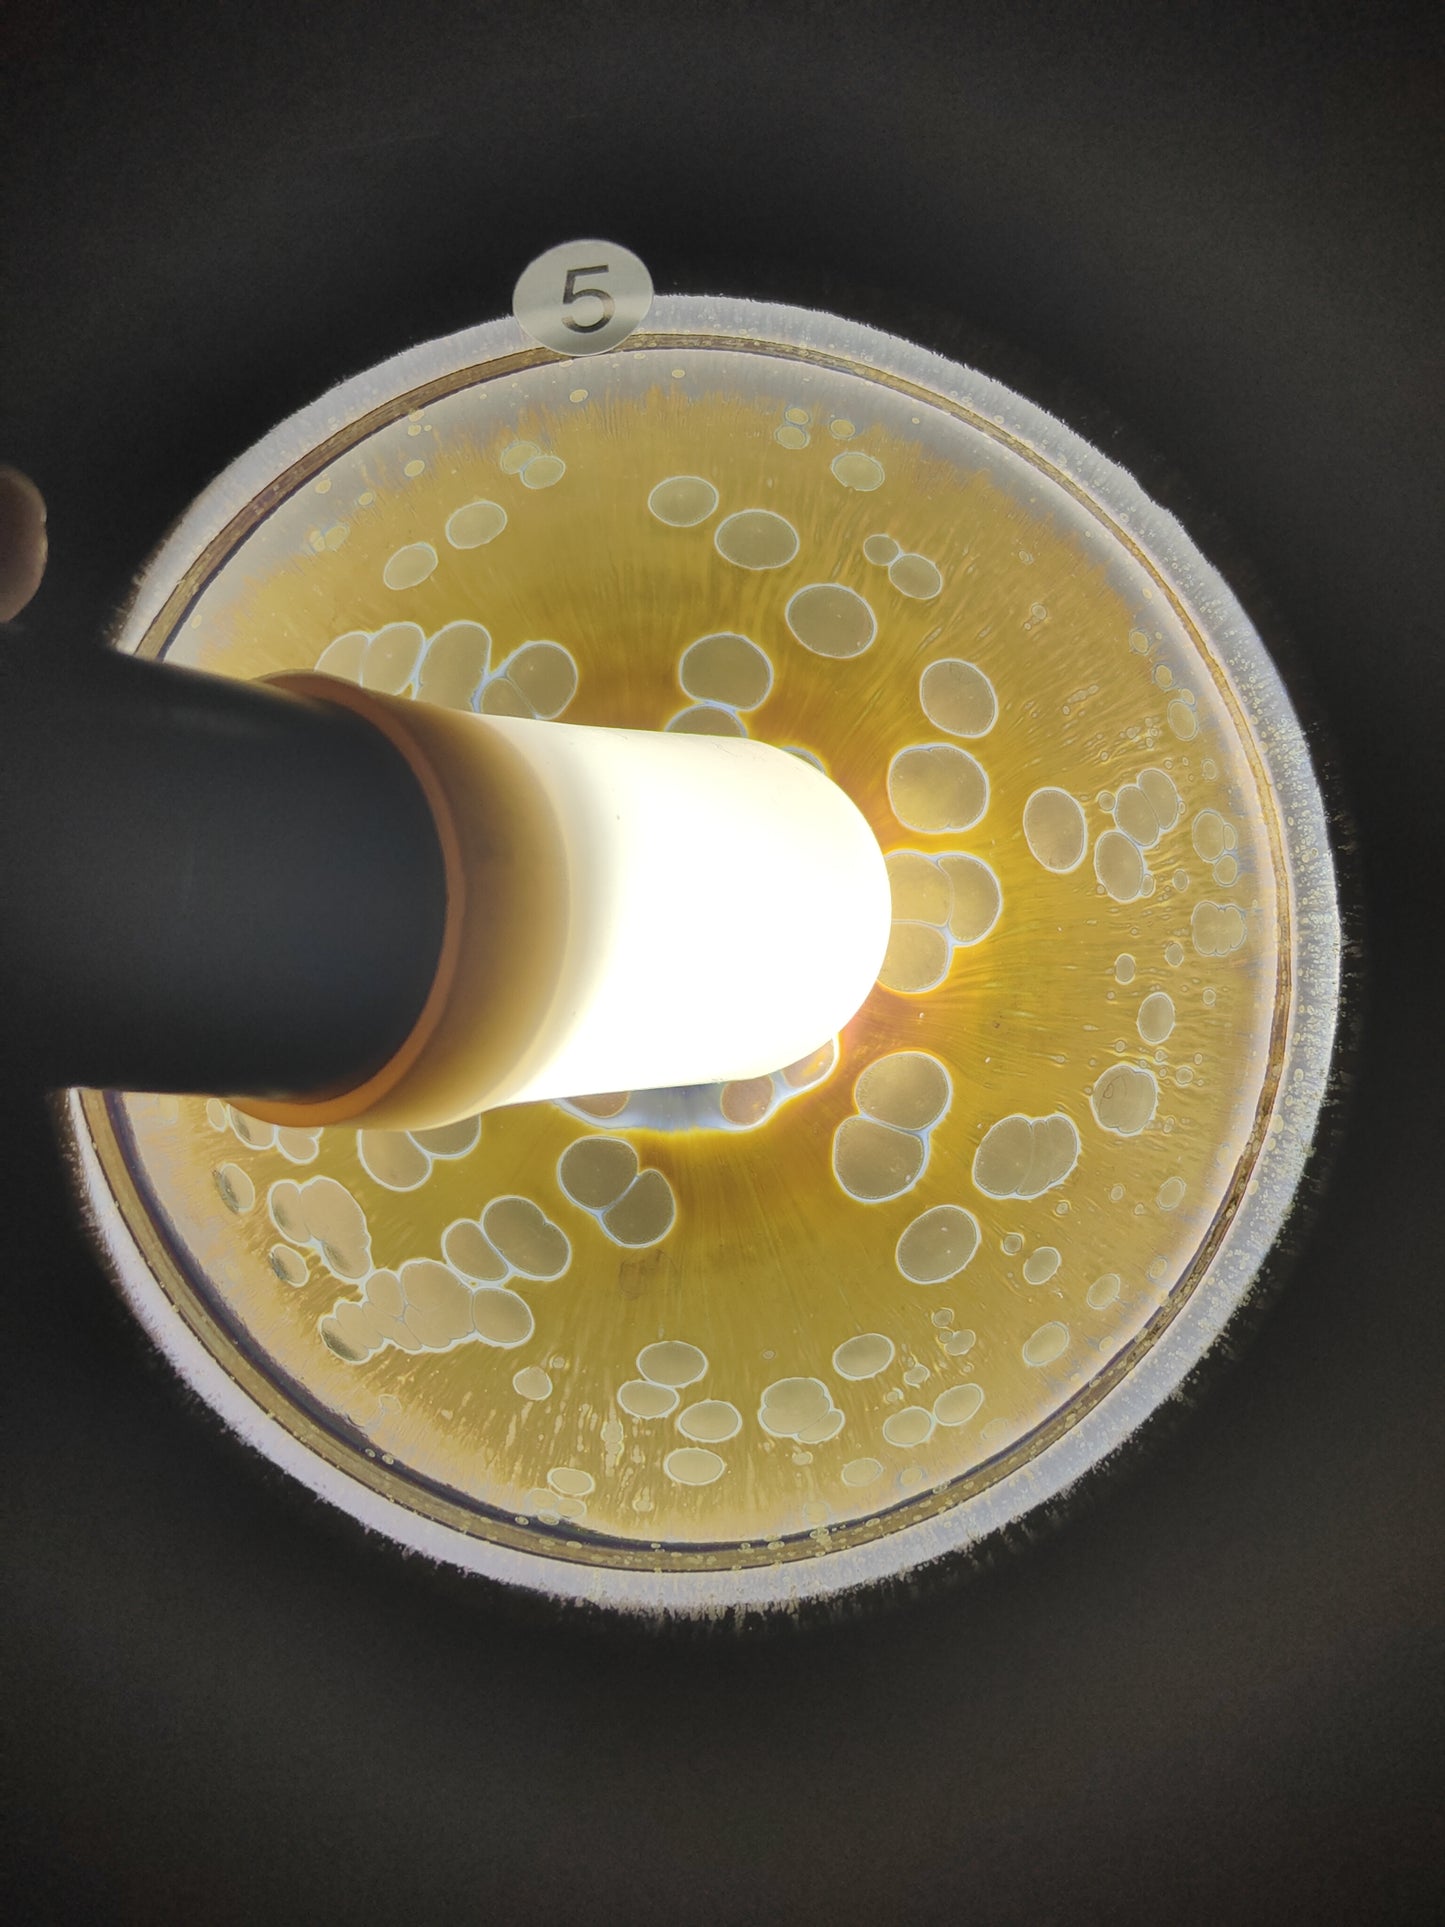
2025-8-11 Master Ye

chinaveins
2025-8-11 Master Ye
2025-8-11 Master Ye
Regular price
$149.00 USD
Regular price
Sale price
$149.00 USD
Unit price
per
Couldn't load pickup availability

































-
Chuan Gu tang
Regular price $988.00 USDRegular priceUnit price per -
Chuan Gu tang Red rust spots
Regular price $899.00 USDRegular priceUnit price per -
Chuan Gu tang Dark Night Blue Oil Drop
Regular price $1,199.00 USDRegular priceUnit price per -
Chuan Gu tang Iron red rust spots
Regular price $899.00 USDRegular priceUnit price per -
Chuan Gu tang Deep BlueOil droplets
Regular price $900.00 USDRegular priceUnit price per -
Chuan Gu tang Red BluePartridge
Regular price $1,390.00 USDRegular priceUnit price per -
Chuan Gu tangRed Partridge Bunch Mouth
Regular price $1,299.00 USDRegular priceUnit price per -
Chuan Gu tang bluePartridge
Regular price $1,200.00 USDRegular priceUnit price per